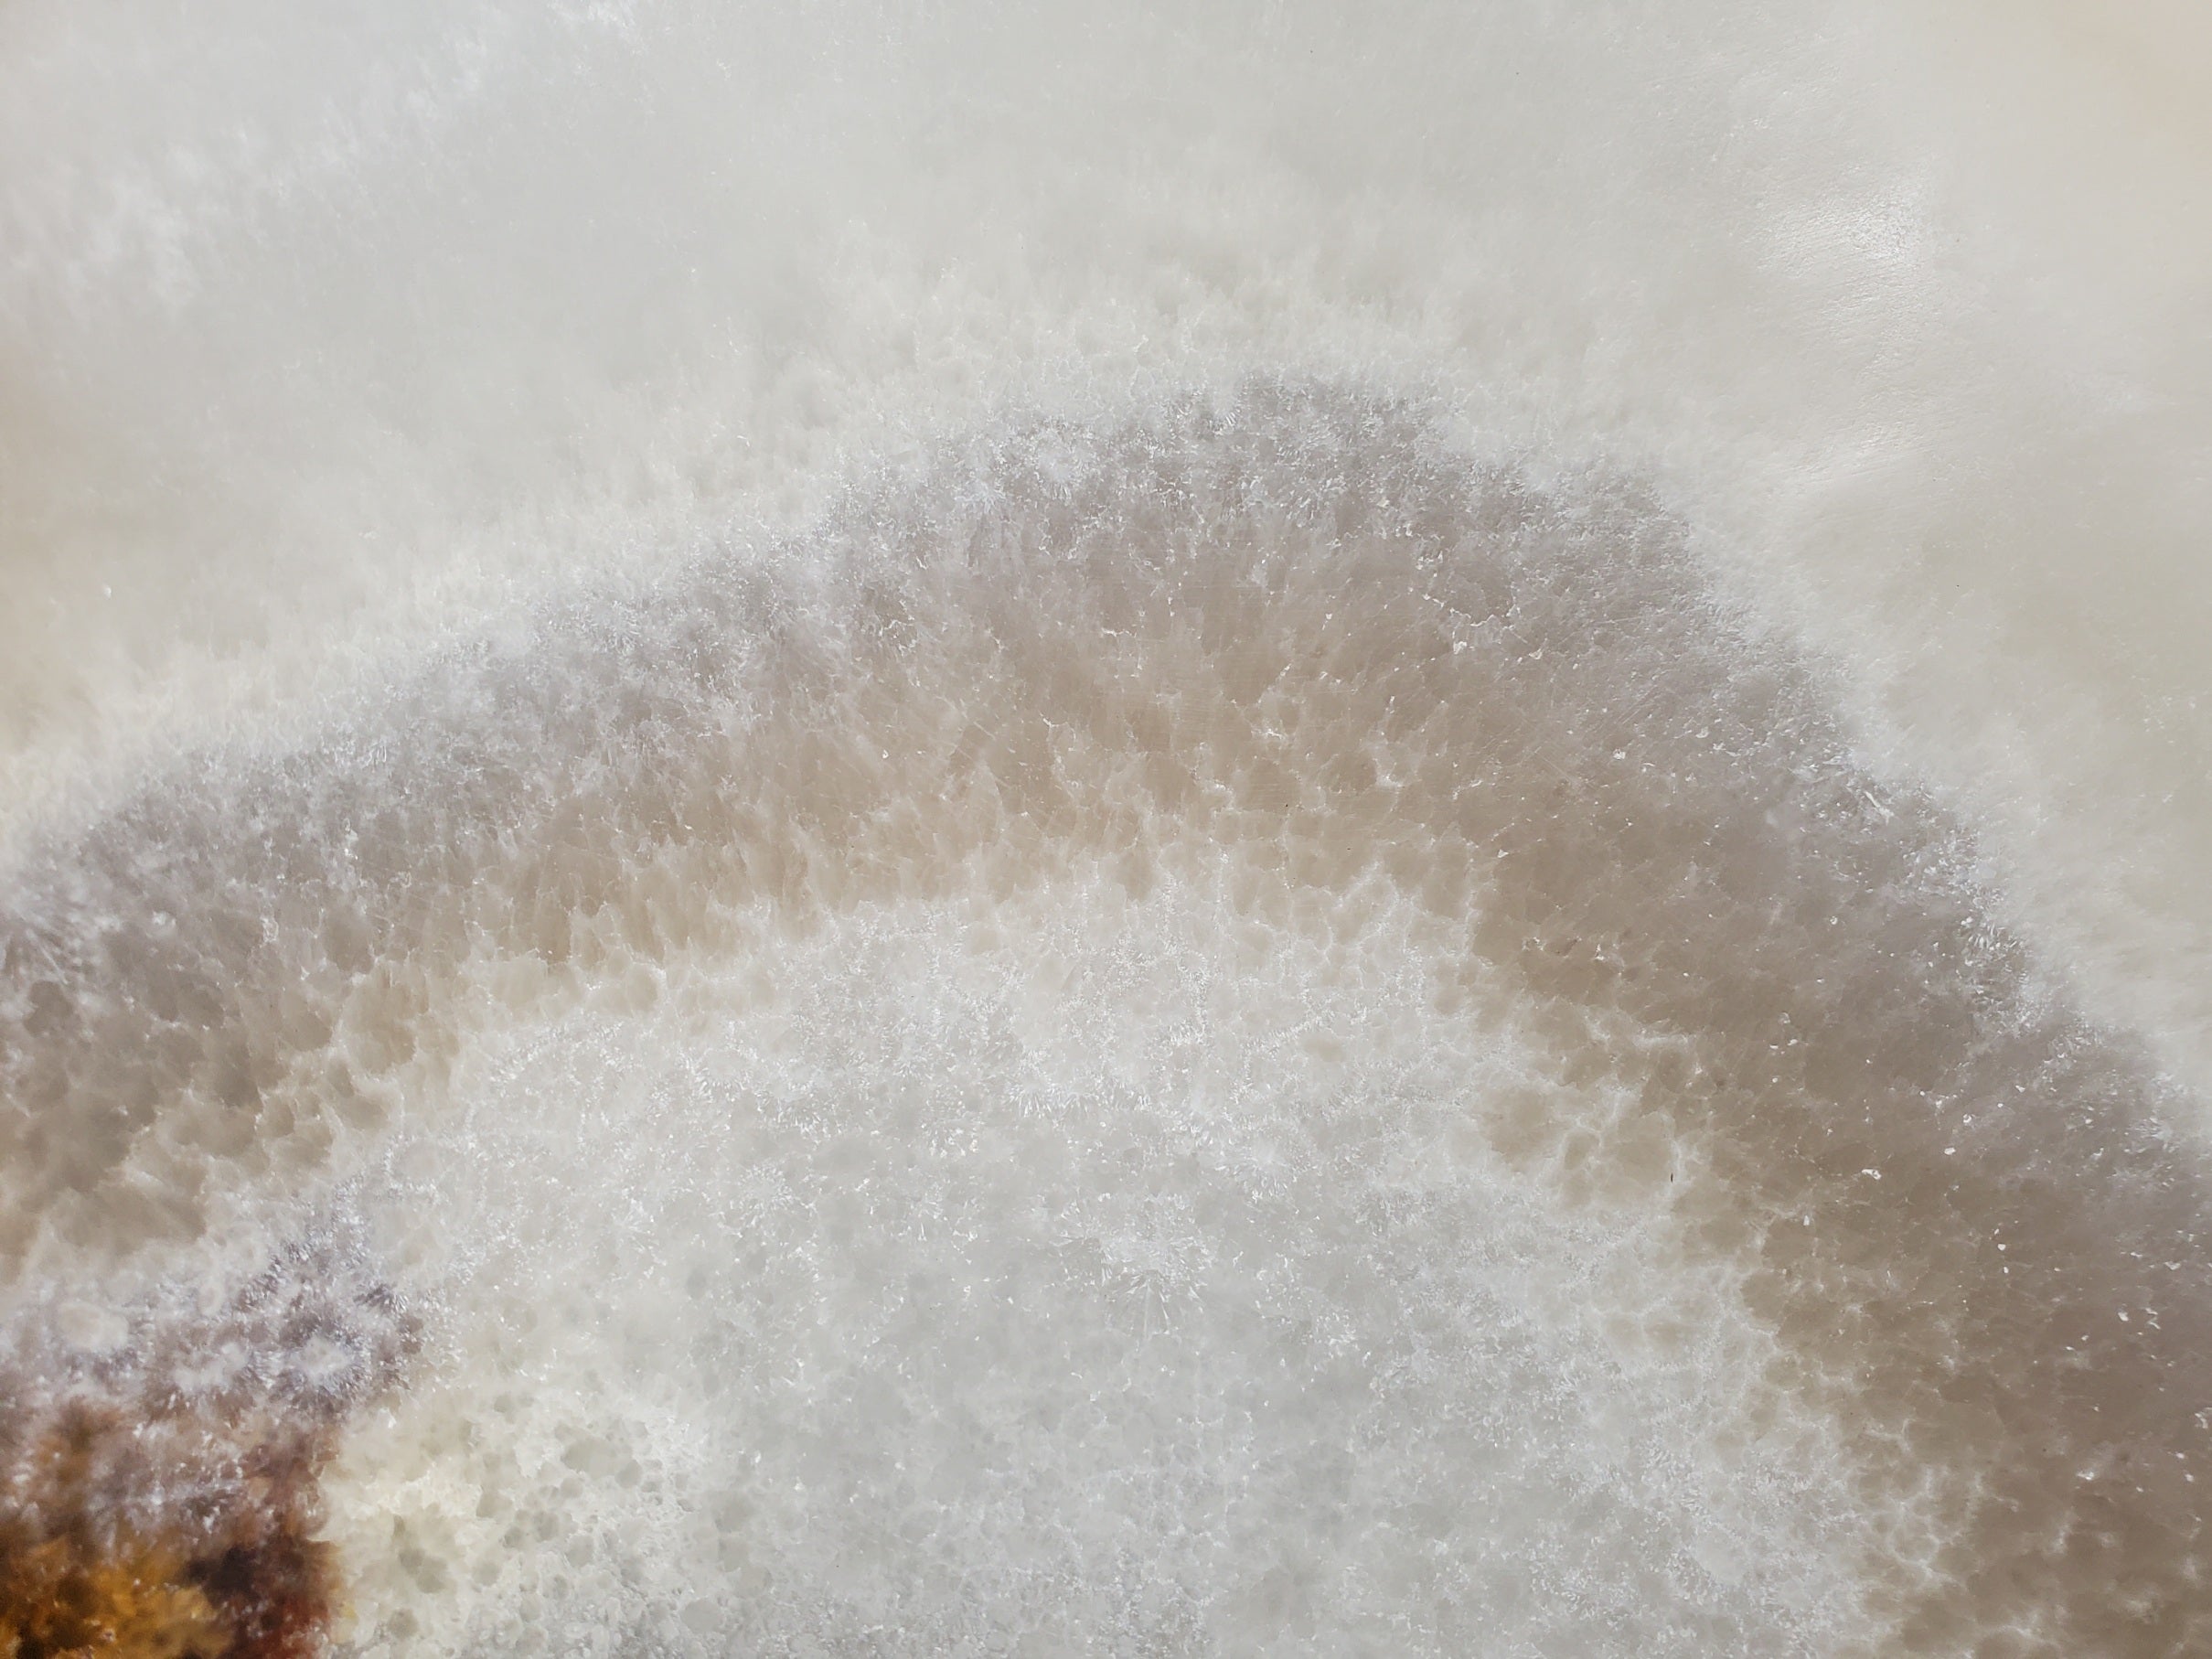
S34_18 Light Green Onyx Bathroom Vessel Sink

S34_18 Light Green Onyx Bathroom Vessel Sink
Experience classic luxury with this gorgeous onyx stone vessel bathroom sink. Crafted from translucent onyx stone, its timeless design refines your space, so experience quality with this timeless piece. You will receive the sink in this picture. It is truly one of a kind. Your purchase supports artisans in Central Mexico.
Dimensions: L 15.2" x W 13" x H 4.8"
Weight: 19.8 lbs.
Drain Hole Diameter: 1- 5/8”
Protective epoxy coating is available for this sink. Epoxy provides additional protection against wear and impermeability and simplifies cleanup. It is a resin coating that brings out the stone’s natural beauty and color variations.
Would you like us to customize your sink’s drain size? If so, click this link and add it to your purchase.
Custom Sink Drain Upgrade – Felipe & Grace (felipeandgrace.com)
We provide care and maintenance instructions.
4084 South 300 West
Murray, Utah 84107
(385) 243-1932
OPEN Mon-Fri 9:30 am - 5 pm MST
Pickup available at Office
Usually ready in 24 hours

S34_18 Light Green Onyx Bathroom Vessel Sink
Polished Stone
Office
4084 South 300 West
Murray UT 84107
United States

Absolutely incredible statement piece! I can't explain how impressive this is.
Pictures do not do justice. It is absolutely stunning! It is perfect.
Exactly as described and beautiful! Very good experience.









